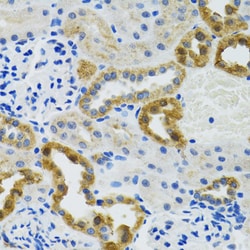
Invitrogen POLG2 Polyclonal Antibody 100 &mu;L; Unconjugated:Antibodies,

Learn More
Invitrogen™ POLG2 Polyclonal Antibody


Rabbit Polyclonal Antibody
Brand: Invitrogen™ PA5110196
Description
Immunogen sequence: HPVFDTKQIR NGVKSIGEKT EASLVWFTPP RTSNQWLDFW LRHRLQWWRK FAMSPSNFSS SDCQDEEGRK GNKLYYNFPW GKELIETLWN LGDHELLHMY PGNVSKLHGR DGRKNVVPCV LSVNGDLDRG MLAYLYDSFQ LTENSFTRKK NLHRKVLKLH PCLAPIKVAL DVGRGPTLEL RQVCQGLFNE LLENGISVWP GYLETMQSSL EQLYSKYDEM SILFTVLVTE TTLENGLIHL RSRDTTMKEM MHISKLKDFL IKYISSAKNV.
This gene encodes the processivity subunit of the mitochondrial DNA polymerase gamma. The encoded protein forms a heterotrimer containing one catalytic subunit and two processivity subunits. This protein enhances DNA binding and promotes processive DNA synthesis. Mutations in this gene result in autosomal dominant progressive external ophthalmoplegia with mitochondrial DNA deletions.
Specifications
| POLG2 | |
| Polyclonal | |
| Unconjugated | |
| POLG2 | |
| AA409516; DNA polymerase gamma; DNA polymerase gamma 2, accessory subunit; DNA polymerase gamma accessory 55 kDa subunit; DNA polymerase gamma subunit 1 (Mitochondrial DNA polymerase catalytic subunit) (PolG-alpha); DNA polymerase gamma, catalytic subunit; DNA polymerase subunit gamma-1; DNA polymerase subunit gamma-2, mitochondrial; DNA-directed DNA polymerase gamma; HP55; MDP1; Mip1; MIRAS; Mitochondrial DNA polymerase accessory subunit; mitochondrial DNA polymerase catalytic subunit; mitochondrial DNA polymerase gamma; mitochondrial DNA polymerase gamma catalytic subunit; mitochondrial DNA polymerase subunit gamma-2; mitochondrial DNA polymerase, accessory subunit; mitochondrial DNA polymerase-gamma; mitochondrial polymerase gamma; mitochondrial polymerase gamma 2; MTDPS4A; MTDPS4B; MTPOLB; p55; PEO; PEOA4; Pol gamma; POLB; POLG; POLG1; Polg2; POLGA; PolG-alpha; POLGB; polG-beta; polymerase (DNA directed), gamma; polymerase (DNA directed), gamma 2, accessory subunit; polymerase (DNA) gamma 2, accessory subunit; polymerase (DNA) gamma, catalytic subunit; polymerase, gamma; polymerase, gamma 2; SANDO; SCAE; truncated mitochondrial DNA polymerase gamma catalytic subunit | |
| Rabbit | |
| Affinity Chromatography | |
| RUO | |
| 11232, 303612, 50776 | |
| -20°C, Avoid Freeze/Thaw Cycles | |
| Liquid |
| ELISA, Immunohistochemistry (Paraffin), Western Blot, Immunocytochemistry | |
| 0.01 mg/mL | |
| PBS with 50% glycerol and 0.02% sodium azide; pH 7.3 | |
| Q9QZM2, Q9UHN1 | |
| POLG2 | |
| Recombinant fusion protein containing a sequence corresponding to amino acids 216-485 of human POLG2 (NP_009146.2). | |
| 100 μL | |
| Primary | |
| Human, Mouse, Rat | |
| Antibody | |
| IgG |
Your input is important to us. Please complete this form to provide feedback related to the content on this product.